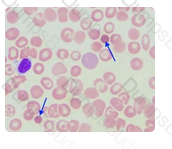
ASCP-MLT Question 58
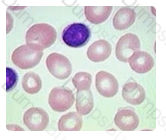
ASCP-MLT Question 74

ASCP-MLT MEDICAL LABORATORY TECHNICIAN - MLT(ASCP) Questions and Answers
Healthcare workers that worked closely with patient specimens were at an increased risk of contracting which viral infection before a vaccine was developed?
Parathyroid hormone regulates serum calcium by acting on bone, kidney, and intestines while regulating phosphate by stimulating the intestines and the kidneys, enhancing absorption and reabsorption respectively.
Chem
The parathyroid hormone is important in the regulation of:
Abrupt change in temperature is one of the risk factors in which a sickling event may occur.
Dehydration, hypoxia, and physical exertion, rather than excessive intake of fluids, inhaling oxygen, and sedentary lifestyle, are all additional risk factors in which sickling events may occur.
Which of these could cause a sickling event?
Macroamylasemia can be diagnosed by measuring amylase levels in the urine and serum. In patients with macroamylasemia, there will be high levels of amylase in the serum. However, macroamylasemia can look similar to acute pancreatitis, which also causes high levels of amylase in the blood. To help differentiate, we measure amylase levels in the urine. Urine levels of amylase are low in people with macroamylasemia, but high in patients with pancreatitis.
The results which would be MOST consistent with macro-amylasemia are?
Listeria monocytogenes is the correct answer. The motility agar is showing motility at the top of the tube, but not deeper; typical of this catalase-positive, gram positive bacillus. Streptococcus agalactiae would be catalase negative and a coccus. Erysipelothrix rhusiopathiae would be H2S-positive and catalase negative. Escherichia coli is a gram negative bacillus.

This Gram-positive bacillus grew as a diffusely beta-hemolytic colony from a newborn. It was catalase positive and had tumbling motility on a hanging drop preparation. This is how it appeared on triple sugar iron agar and motility medium. What is the most likely diagnosis?
hs-CRP is a recent marker of chronic inflammation. New measurements of CRP in lower levels (hs-CRP) are now measured to monitor risk of cardiovascular disease.
Select the statement that best describes hs-CRP?
Ferritin and hemosiderin are considered storage forms of iron.
Which substance(s) is/are considered iron storage compounds?
Alkaline over acid, or K/A, in TSI reactions is associated with the fermatation of glucose alone and the utilization of peptone.
Which of the following sugars has been fermented by a gram-negative rod that has produced an alkaline slant and an acid butt on triple sugar iron agar (TSI).?
A zone of inhibition is the area around an antibiotic-infused paper disk that does not show any bacterial growth. The antibiotic impregnated on the disk will diffuse into the agar in the area surrounding the disk. If the bacteria are sensitive to the antibiotic, they cannot grow near the disk. The size of the zone is proportional to how sensitive the organism is. If the organism is resistant to the antibiotic, it will grow very closely to the disk.
The size of the zone of suppressed growth on a sensitivity plate using sensitivity disks is referred to as the zone of:
Ammonium biurate crystalsare typically round, irregularly spiked and yellow-brown in color.
A microscopic examination of a normal urine pH 8.0 shows 2+ yellow-brown thorny spheres which are MOST probably:
What two glycoproteins are expressed on the surface of influenza A viruses and are used for subtyping of the viruses?
The morphologic characteristic(s) associated with the Chediak-Higashi syndrome is (are):
Once substance H is developed, the addition of the sugar N-acetylgalactosamine to the terminal position of the chain gives the molecule "A" antigenic activity.
Which specific terminal sugar causes a red cell to have A antigenic activity?
This type of laboratory testing provides immediate assessment of the patient and can be performed at their bedside:
Estriol levels in conjunction with hCG and AFP can be obtained during pregnancy to:
CD34, a cell surface marker, presents on undifferentiated pluripotential hemopoietic stem cells. CD34 is a cell surface glycoprotein and functions as a cell-cell adhesion factor.
Which one of the following antigen markers is BEST associated with stem cells?
What has happened in a titer, if tubes #5-7 show a stronger reaction than tubes #1-4?
Assuming an alpha hemolytic reaction (not well seen in the image), viridans streptococcus and S. pneumoniae are the two possible responses. However, these colonies are far too mucoid for viridans streptococci; therefore, S. pneumoniae is the most likely choice. Also, the colonies are much too large and the hemolytic reaction is wrong for S. pyogenes or S. agalactiae.
A patient was admitted to the hospital recently with an obvious infection. A sputum specimen was submitted and the microbiologist inoculated it to sheep blood agar. Based on the colony morphology and the alpha hemolysis seen in the image to the right, the most likely identification is:

Unconjugated bilirubin is a byproduct of RBC breakdown, or hemolysis. It would be expected to see an increase in unconjugated bilirubin when hemolysis is occuring at an increased rate. The liver enzymes would not remain at normal levels if there were a viral infection of the liver, chemical damage to the liver, or obstruction of bile ducts.
Chemistry
A patient presents with an elevation of unconjugated bilirubin, normal serum alkaline phosphatase, normal liver enzymes, and no bilirubin in the urine. This combination would suggest:
Following an accidental needlestick, the person should be tested for all of the following except:
The image shown in this question is depicting a rosette formation. Here the red blood cells are surrounding and adhering to the outside of the white blood cell.

What is the best description of the phenomenon seen in this illustration?
Which of the following agencies administers the certification test that you will be eligible to take at the end of your 4 semester?
UA & Body Fluids
What is the identification of this crystal seen in a urine with an alkaline pH?

Conversion of only the slant to a pink color in a Christensen's urea agar slant is produced by bacterial species that have weak urease activity. The reaction in the slant to the right is often produced by Klebsiella species, as an example. Strong urease activity is indicated by conversion of the slant and the butt of the tube to a pink color, as seen in the tube to the left. The slant only reaction in the right tube may be seen early on if only the slant had been inoculated; however, with a strong urease producer, both the slant and the butt would turn. Therefore, the reaction is dependent on the strength of urease activity. If the media had outdated for a prolonged period, either there would be no reaction or the appearance of only a faint pink tinge, either in the slant, the butt or both, again depending on the strength of urease production by the unknown organism.
The urease reaction seen in the Christensen's urea agar slant on the far right indicates:

Coumarin derivatives inhibit the vitamin K dependent Factors (II, VII, X) which can be measured with the PT and monitored frequently with the INR assay.
Hematology
Warfarin-based (coumarin derivative) oral anti-coagulant therapy is commonly monitored with :
Vitamin K dependent factors are those that require Vitamin K for their synthesis in the liver. Vitamin K is an important factor to gamma-glutamyl carboxylase which adds a carboxyl group to glutamic acid residues on factors II, VII, IX and X, as well as Protein S, Protein C. In adding the gamma-carboxyl group to glutamate residues on the immature clotting factors Vitamin K is itself oxidized. Deficiency of Vitamin K due to malabsorption, liver disease, etc. may contribute to bleeding disorders because clotting factor maturation depends on Vitamin K.
Which of these coagulation factors are referred to as "vitamin-K dependent?"
In DNA complementary base pairing, guanine and cytosine pair and adenine and thymine base pair. Remembering the phrase "G-CAT" helps one recollect correct pairing.
Which nitrogen base would bind with a guanine nucleotide in forming double-stranded DNA?
This patient is most likely suffering from an immediate-acting coagulation inhibitor; most commonly, lupus anticoagulant. Notice that the addition of normal pooled plasma does not correct upon initial or incubated mix, which means that the inhibitor is not time or temperature-dependent.
Factor VIII is not the correct answer as a factor deficiency would have corrected upon the addition of normal pooled plasma. Factor VII is not the correct answer, as the aPTT assay does not account for factor VII activity or concentration.
The laboratorian completed the mixing study ordered for John Doe. The results are as follows:
Initial aPTT result: 167 seconds
Initial 1:1 Mix with Normal Pooled Plasma: 158 seconds
Incubated 1:1 Mix with Normal Pooled Plasma: 150 seconds
Which of the choices below would most likely explain the results for this patient?
Convert the following temperature from Celsius to Fahrenheit
20 degrees C
Question options:
Entamoeba gingivalis resembles Entamoeba histolytica both in size and in nuclear characteristics. Entamoeba gingivalis may contain numerous cytoplasmic inclusions such as red blood cells, white blood cells, and bacteria.

I reside in the mouth where I measure approximately 17 micro meters.
Which of the following disorders is characterized by increased production of chloride in sweat?
Multiple myeloma
Heparin is the additive of choice for blood gas syringe collection as it has the least amount of interference with the blood gas analytes measured.
Which of the following additives should be used for the collection of a sample for blood gas analysis:
In which of the following laboratory situations is a verbal report permissible?
Waived tests are those considered to have an insignificant risk of erroneous results. Which of the following is NOT an example of a waived test?
What is the best description of the purpose of the Commission on Office Laboratory Accreditation (COLA) pertaining to the clinical laboratory?
HLA-DR is a class II MHC.
HLA-A, HLA-B, and HLA-C are all class I MHC.
Which of the following antigens is classified as a Major Histocompatibility Complex
Class II antigen (MHCII)?
The deposition of plaques containing cholesterol and lipids on the innermost layer of the walls of large and medium-sized arteries is the defintion of atherosclerosis.
Arteriosclerosis is a more general term that describes a thickening and loss of elasticity of the walls of the arteries (hardening of the arteries). Atherosclerosis is a type of arteriosclerosis but is not synonymous with it.
Atherosclerosis is not the most common outcome for risk marker studies because it can be hard to measure. Infarcts, cardiac procedures, death, and 'events' are more common. Most humans have visible or measureable atherosclerosis by early middle age.
Chemistry
Which of the following is true concerning atherosclerosis?
AABB Standards do not require a DAT, autologous control, or a minor crossmatch for pretransfusion testing.
Essential components of compatibility testing include all of the following except :
The DAT is most likely to be negative in ABO HDFN. It's possible that the washing done as part of the DAT may break the bonds between anti-A (or anti-B) and the newborn's poorly developed A (or B) antigens.
For which of the following antibodies is the DAT most likely to be negative when testing a newborn for possible HDFN?
IgE levels are often increased in patients with allergic disease. IgE binds to the membranes of mast cells and basophils, and if specific antigen is present to react with the IgE molecule, degranulation of these cells occurs, releasing histamines, and other substances into the blood or tissues.
Which of the following immunoglobulin classes is chiefly responsible for the degranulation of mast cells and basophils:
Malbranchia species share the production of alternate staining arthroconidia as a common feature with the mold form of Coccidioides immitis.
Both Geotrichum species and Trichosporon species produce rectangular-shaped arthroconidia; however, they are regularly rather than alternately staining. Additionally, the arthroconidia of Geotrichum may produce germ tubes from one corner and the arthroconidia of Trichosporon species may produce blastoconidia from adjacent corners, features not shared by either Malbranchia species or Coccidioides immitis.
The hyphae of Microsporum canis, as seen in direct KOH mounts of skin scales, may break up into arthroconidia; however, they are much narrower in dimension and do not share the alternate staining characteristics.
Microbiology
The hyaline saprobic fungus that has microscopic features similar to the mold form of Coccidioides immitis is:
Nucleated RBCs may be seen in the peripheral blood in cases of beta thalassemia major. Nucleated RBCs are usually not found in peripheral blood in cases of beta thalassemia minor and beta thalassemia intermedia, and would not be a finding in beta thalassemia minima.
Nucleated RBCs are most likely to be seen in the peripheral blood of which of these beta thalassemias?
Which of the following is NOT part of the magnification system of the microscope?
Cerebrospinal fluid has three main functions:
Protect brain and spinal cord from trauma.
Supply nutrients to nervous system tissue.
Remove waste products from cerebral metabolism.
Which of the following are functions of CSF? Please select all correct answers
The conidia of Exophiala species are produced within phialides that extrude the conidia in tight, ball-like clusters.
The large, drum stick-shaped muriform macroconidia of Alternaria species are arranged in short chains; the small, elliptical conidia of Cladosporium species are arranged in both long and short, branching chains.
Which of the following dematiaceous fungal species produce conidia in clusters?
Bone marrow biopsies are helpful diagnostic tools in:
Evaluation of anemia and thrombocytopenia
Evaluation of cytopenias
Diagnosing leukemias
Can be part of evaluation for FUO
Bone marrow biopsies are NOT used as screens for hematologic issues during routine check-ups.
Hematology
In which of the following situations would a bone marrow aspirate and biopsy possibly be used as an aid for diagnosis? (Select all that apply)
The cells indicated by the arrows in the image are spherocytes. Spherocytes have a decreased surface to volume ratio and are therefore smaller with an increased MCHC. Spherocytes have lost their bi-concave shape and are spherical in shape, hence the name.
What are the cells that are indicated by the arrows in this peripheral blood smear image?
Shigella and Salmonella are not found as normal flora in the gastrointestinal tract.
Which of the following are not considered normal flora of the gastrointestinal tract:
Glucose positive, Maltose positive, Lactose negative and Sucrose negative is the correct answer since Neisseria meningitides causes Waterhouse-Friderichsen syndrome and it is positive only for glucose and maltose.
An autopsy of a 1-year-old female admitted to the emergency room 4 hours prior to her death revealed Waterhouse-Friderichsen syndrome. Blood and nasopharyngeal cultures taken prior to her death should reveal an oxidase-positive, Gram-negative diplococcus with the following biochemical reactions:
The part of the microscope that holds the objective lenses is called the _______________.
The body compensates for alkalosis or acidosis of the blood PRIMARILY to regain a normal pH, between 7.35 - 7.45.
When the body compensates for a respiratory or metabolic disorder, the MAIN goal is to achieve:
Transfusion of red cells of any ABO type other than O to a group O patient is of course likely to cause a hemolytic transfusion reaction.
Which of the following types of packed RBCs could be transfused to a group O patient:
HbA1C is the recommended test for monitoring diabetic carbohydrate management. Microalbuminuria, low concentrations of urinary albumin, is measured to detect early renal impairment, at a stage where it is reversible with treatment.
What is the role of microalbuminuria testing?
A casual blood glucose >/= 200 mg/dL on a patient with symptoms and an A1C >/= 6.5% meet diagnostic criteria for diabetes.
Chemistry
A physician is evaluating a 45-year-old obese male for diabetes and orders a plasma glucose at time of evaluation and a HbA1C one week later. The patient has a family history of diabetes and currently exhibits symptoms of diabetes.
What would be the best course of action if these are the blood glucose results?
Casual Blood Glucose: 208 mg/dL
HbA1C one week later: 7.2%
In excess triglycerides, the triglycerides reduce the amount of cholesterol in LDL particles producing small dense LDL molecules. Because of size and density, these molecules more easily enter damaged endothelium and vessel walls and are more easily incorporated as plaque is formed.
Which statement best describes small dense LDL particles that can occur in atherogenic dyslipidemia?
The color coding of evacuated tubes provides information about all of the following except the: Question options:
The combination of complement C4, C2 and C3 that binds to the antigen-antibody complex in the initial reaction step in the classical pathway of complement activation is called the activation unit.
Which of the following is the "activation unit" in the classical complement pathway?
Public health guidelines recommend that manipulation of samples for influenza testing be done inside a safety cabinet. Safety goggles could be worn if the specimen or procedure may be prone to splashes or sprays of infectious material. Utility gloves are not necessary.
Public health guidelines recommend that laboratory specimens for influenza testing must be manipulated using which of the following safety precautions?
Hemolytic anemia, myelodysplasia, and liver disease may each fit this peripheral blood picture. Each of these conditions can display peripheral blood macrocytosis. It is easy to observe the overall larger size of the red blood cells in this image compared to the normal lymphocyte also present.
When macrocytes are present, they should be examined for their shape (round vs. oval), the hemoglobin content (central pallor), and whether or not there are any inclusions present in the cell.
Iron deficiency would not be the correct answer in this case, since this condition is associated with microcytosis instead.
The complete blood count was obtained from a patient recently admitted to the emergency room. The red blood cell indices obtained revealed an MCV of 115 femtoliters (fL) (normal range 80 - 90 fL). The patient met the criteria for a peripheral blood smear examination. A representative field is shown on the right.
Which of the following conditions may be indicated by the results seen on this peripheral blood smear?
Troponin is a very specific biomarker that is released during cardiac injury or stress. CK is found not only in cardiac tissue, but also in muscle and brain tissue. LD levels can be elevated in cardiac events, tissue breakdown, and hemolysis. Myoglobin is elevated when muscle tissue is damaged and is not specific for the heart muscle.
Chemistry
Which one of the following is the MOST specific biochemical marker of myocardial infarction?
A patient is admitted to the hospital with acute chest pain, but which of the following enzymes will be elevated FIRST if the patient had an MI?
Albumin is a "negative" acute phase protein since it is found in decreased levels during acute phase response. Alpha-1-antitrypsin, fibrinogen, and ceruloplasmin are all "positive" acute phase proteins that are found in increased levels during acute phase response.
Which one of the following usually shows a decrease during an acute phase response?
HLA-DR is a MHC class II(major histocompatibility complex) surface receptor on the cellular surface which is encoded by the human leukocyte antigen complex, or HLA.
DR antigens are found in which of the following systems:
This patient is most likely suffering from sickle cell anemia. This cell, which is sickle-shaped, is indicative of the presence of hemoglobin S. Polychromasia is also commonly observed in sickle cell anemia.
After experiencing crippling pain in her chest, Elizabeth's mother rushes her to the Emergency Room. After a complete blood count and differential are ordered, the hematology technologist views many peripheral cells similar in appearance to those found in the image below. Which condition is most likely present?
As maturation continues in the granulocytic series the nucleus of the metamyelocyte becomes kidney or bean shaped.
Identify the cell in this illustration indicated by the arrow:

The results of this PT and aPTT are in normal range. These results can be reported and are not indicative of the need to: order a mixing study or request a redraw.
You have just performed stat PT and aPTT tests on your coagulation instrument. Your results are as follows:
PT = 12 seconds (normal range 10-13 seconds)
aPTT = 24 seconds (normal range 21-34 seconds)
What would be your next step?
Immunoassay is the most common technique that is used by clinical laboratories for therapeutic drug monitoring.
Most of the drugs commonly assessed with TDM can be measured on analytical platforms which utilize antibodies (in some form) for detection. Antibodies can be developed that recognize drugs. Although most drugs are much too small to evoke an immune response, scientists can conjugate drugs to immunogenic proteins to produce antibodies that recognize drug-specific epitopes.
Which of the following is the most common technique that is used by clinical laboratories for therapeutic drug monitoring?
The cells are plasma cells. They are larger than normal small lymphocytes with more abundant cytoplasm. The cytoplasm is more basophilic than the cytoplasm of a normal lymphocyte and a well-defined perinuclear halo (clearing in the golgi area) is noticeable. The nucleus is eccentrically placed. Plasma cells are counted in a separate category on a bone marrow differential.

Hematogones are blast-like cells that are more mature than lymphoblasts. They are usually tallied with lymphocytes when performing a bone marrow differential.
What are the cells that are indicated by the red arrows in the image on the right?
An antithetical relationship exists between the antigens M and N. Antithetical relationships occur in situations where for a given locus, only one of two genes may be inherited, the alleles are termed antithetical alleles.
In immunohematology, an antithetical relationship exists between M antigen and which of these antigens?